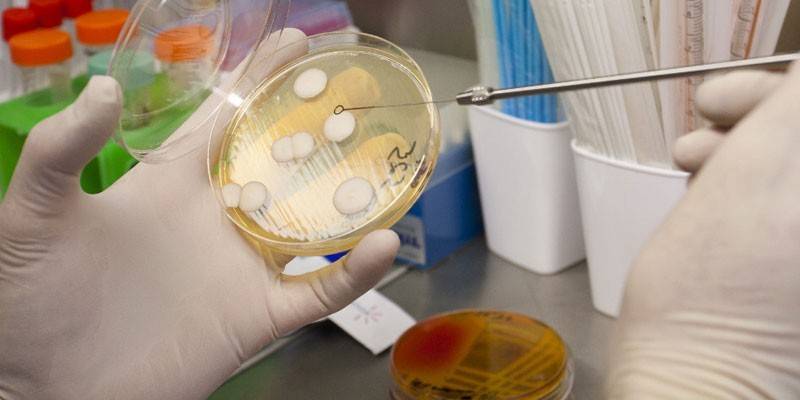

Streptococcus viridans: tratamiento en humanos
Las bacterias invisibles a simple vista pueden causar procesos inflamatorios graves. ¿Por qué el rápido desarrollo de microorganismos es virida, cómo afecta este estreptococo a la salud humana? Es útil conocer los síntomas de las lesiones infecciosas, los métodos para diagnosticar y tratar enfermedades.
¿Qué es Streptococcus viridans?
Los microorganismos más simples son una parte importante de la microflora del cuerpo, participan en el trabajo de sus sistemas. Streptococcus viridans (Streptococcus de Viridans) no es peligroso, se considera oportunista mientras una persona está sana. Las bacterias se encuentran con mayor frecuencia en la cavidad oral, pero pueden localizarse en los órganos:
- sistema genitourinario;
- tracto gastrointestinal;
- sistema respiratorio
Con una disminución en las defensas del cuerpo, se produce la propagación activa de estreptococos. Las bacterias Viridans tienen tales características:
- llegar a una persona con comida, durante el tratamiento dental, con intervención quirúrgica;
- con una disminución de la inmunidad, causan infecciones que se caracterizan por un curso severo;
- Entrar en el sistema circulatorio, diseminarse por todo el cuerpo, afectar órganos distantes, causar hemólisis (destrucción de las células sanguíneas).
Los estreptococos son resistentes a las influencias ambientales. Las bacterias viridanas caracterizan tales propiedades:
- Los microorganismos que se encuentran en la sangre, el esputo, pueden permanecer viables durante varios meses.
- Cuando se expone a temperatura más 60 grados, la bacteria muere en media hora.
- El procesamiento con soluciones desinfectantes destruye viridans después de 15 minutos.
Que enfermedades provoca
Cuando, por diversas razones, se produce una fuerte disminución de la inmunidad, el estreptococo comienza a multiplicarse rápidamente y a extenderse por todo el cuerpo. La pequeña bacteria viridans infecta las células de los órganos, causando enfermedades graves. El paciente puede desarrollar:
- miositis (proceso inflamatorio de los músculos esqueléticos);
- infección por erisipela;
- daño a las articulaciones, músculos;
- uretritis (inflamación de la uretra);
- absceso de tejidos blandos;
- fascitis (espolón calcáneo);
- pielonefritis, nefritis (procesos inflamatorios en los riñones);
- Cario daño dental.
Streptococcus viridans en la garganta puede provocar faringitis (inflamación de la membrana mucosa de la faringe), amigdalitis (lesión purulenta aguda de las amígdalas). Al multiplicar microorganismos, no se excluye la aparición de tales enfermedades:
- enfermedad periodontal;
- bronquitis
- linfadenitis (inflamación purulenta de los ganglios linfáticos);
- escarlatina
- hinchazón de las orejas;
- neumonía
- estreptoderma (lesiones purulentas de la piel);
- otitis media;
- meningitis (inflamación de las meninges);
- reumatismo
- cervicitis (inflamación del cuello uterino);
- infecciones invasivas después de quemaduras;
- sepsis posparto.
Los microorganismos pueden causar una forma aguda de endocarditis infecciosa. Streptococcus y Staphylococcus viridans, que se instalan en las válvulas de las válvulas del corazón, conducen a su deformación. Los pacientes en esta situación pueden desarrollar:
- embolia microbiana de los vasos sanguíneos (restricción del flujo sanguíneo debido a una disminución de su luz), como resultado: ataque cardíaco, accidente cerebrovascular;
- absceso (inflamación purulenta) del cerebro;
- aneurisma (protrusión) de las arterias;
- insuficiencia cardíaca
- encefalopatía (daño cerebral).

Síntomas
Los procesos inflamatorios se están desarrollando rápidamente, por lo que es importante que cuando vea signos de la enfermedad busque ayuda de los médicos. El tratamiento oportuno ayudará a evitar consecuencias peligrosas. Con la propagación de Streptococcus viridans, se observa un aumento de la temperatura a valores subfebriles (aproximadamente 37,5 grados). Los siguientes síntomas pueden hablar sobre el comienzo del desarrollo de procesos patológicos:
- erupciones cutáneas alérgicas;
- disminución del rendimiento;
- malestar general;
- falta de apetito
- fiebre
- escalofríos
- debilidad
- náuseas
- apatía
La infección del cuerpo con estreptococos viridans a menudo se acompaña de la aparición de signos de la enfermedad, que dependen de la ubicación de la infección:
La enfermedad |
Lo que sorprende |
Síntomas |
Faringitis |
Mucosa faríngea |
dolor de garganta enrojecimiento incomodidad al tragar |
Estreptoderma |
Piel integumento |
erupción pustulosa |
Dolor de garganta |
Amígdalas |
dolor de garganta placa purulenta en las amígdalas ganglios linfáticos submandibulares agrandados |
Periodontitis |
Las encías |
hinchazón sangrado |
Bacterias str. Los viridanos causan infecciones graves en las que se puede observar el siguiente cuadro clínico:
La enfermedad |
Lo que sorprende |
Síntomas |
Erisipela |
Integumentos, mucosas |
fiebre alta, enrojecimiento de la piel burbujas fluidas |
Bronquitis |
Bronquios |
signos de intoxicación tos severa falta de aliento |
Neumonía |
Pulmones |
|
Linfadenitis |
Ganglios linfáticos |
dolor aumentar de tamaño |
Uretritis |
Uretra |
dolor al orinar fiebre |
Cervicitis |
Cuello uterino |
flujo vaginal |
Cuando los estreptococos ingresan al torrente sanguíneo y se extienden por todo el cuerpo, no se excluye el desarrollo de patologías peligrosas que se acompañan de tales síntomas:
La enfermedad |
Lo que sorprende |
Síntomas |
Otitis |
Oreja |
secreción purulenta dolor punzante |
Meningitis |
Membranas cerebrales |
conciencia alterada dolores de cabeza vómitos delirio |
Endocarditis |
Válvulas cardíacas |
fiebre transpiración fuerte palidez |
Caries |
Dientes |
rotura del esmalte dolor |
Diagnósticos
Cuando un paciente acude al médico con síntomas de infección, es necesario determinar qué patógeno causó la enfermedad. Para identificar el estreptococo, puede realizar una prueba rápida, que dará un resultado en unos minutos. Es importante asegurarse de que la patología provocó viridans. Para esto, tales análisis se llevan a cabo:
- Cultivo bacteriológico: establece el tipo de bacteria, su sensibilidad a los antibióticos.
- Reacción en cadena de la polimerasa (PCR): determina el patógeno por partículas de ADN.
Para realizar una prueba de viridans estreptocócica, se necesita biomaterial para la investigación.Puede ser sangre, orina, secreción de los genitales; depende de la enfermedad, la localización de la infección. Para el diagnóstico de viridans por el método de inoculación bacteriana, se toma el material:
- con cervicitis, un frotis de la vagina;
- en caso de lesiones de la piel: raspado de tejido;
- con síntomas de infecciones de la cavidad oral: un frotis de la membrana mucosa de la laringe, faringe, amígdalas.
La elección correcta de biomaterial ayudará a los médicos a hacer un diagnóstico preciso. Para la investigación, es necesario tomar del paciente:
- en caso de sospecha de sinusitis: un frotis de la membrana mucosa de la cavidad nasal;
- con patologías renales: orina para análisis;
- para el diagnóstico de enfermedades respiratorias: bronquitis, neumonía, esputo;
- con endocarditis, sepsis: sangre de una vena.
Después de realizar las pruebas, el médico elige el régimen de tratamiento. En el tratamiento de infecciones causadas por Streptococcus viridans, se necesita un enfoque integrado. El médico prescribe a los pacientes:
- antibióticos del grupo de penicilinas, cefalosporinas, sulfanilamidas, macrólidos para eliminar bacterias dañinas;
- inmunomoduladores - para mejorar la inmunidad local - IRS-19, Imudon en forma de aerosol para la garganta, para administración oral - Ergoferon, Ingaverin;
- terapia de vitaminas;
- hacer gárgaras con decocciones de hierbas;
- dieta digestible
Un papel importante en el tratamiento de infecciones causadas por la bacteria Streptococcus viridans es la eliminación de toxinas del cuerpo, la restauración de la microflora. Para esto, se recomiendan las siguientes actividades:
- Beber una gran cantidad de líquido en forma de agua, bebidas de frutas, jugos, té, hasta tres litros por día.
- Restauración de la microflora, alterada por el uso de agentes antibacterianos, fármacos bififormes, Linex.
- Recepción de enterosorbentes con acción antimicrobiana, desintoxicante, bacteriostática: fármacos Atoxil.
Tratamiento antibiótico
Una infección causada por Streptococcus viridans no se puede tratar sin el uso de medicamentos antibacterianos. Para el tratamiento, se usan antibióticos de varios grupos. Las bacterias son sensibles a los medicamentos de penicilina, por lo tanto, estos medicamentos a menudo se recetan:
- Ampicilina
- Piperacilina;
- Oxacilina;
- Amoxicilina;
- Bicilina-3;
- Bencilpenicilina.
Si la bacteria viridans afecta la garganta, se usa un antibiótico tópico en forma de aerosol: Bioparox. Cuando se observa una infección de un grupo de penicilina en una infección causada por estreptococo en un paciente, los médicos prescriben:
- cefalosporinas - Cefalexina, Cefazolina, Suprax;
- macrólidos: azitromicina, eritromicina, claritrosina;
- sulfonamidas: sulfadimidina, sulfacetamida, sulfalen.
Para un tratamiento exitoso, los viridanos requieren estreptococos para ser sensibles a los antibióticos. Los medicamentos iniciales incluyen ampicilina del grupo de penicilina, que tiene un amplio espectro de acción contra los patógenos. De acuerdo con las instrucciones, esta herramienta se distingue por:
- indicaciones de uso: infecciones bacterianas de la piel, sistema respiratorio, sistema genitourinario;
- dosis para adultos: tabletas de hasta 500 mg, 4 veces al día, inyecciones después de 6 horas, la dosis se prescribe individualmente.
La duración del tratamiento depende de la condición del paciente, la establece el médico. El medicamento Ampicilina para la infección, una llamada de estreptococo viridans, tiene características:
- contraindicaciones de uso: patología hepática, intolerancia a la penicilina, leucemia linfocítica;
- efectos secundarios: urticaria, náuseas, candidiasis de la cavidad oral, disbiosis;
- instrucciones especiales: es necesario usar simultáneamente drogas para restaurar la microflora.
En caso de intolerancia a los antibióticos de tipo penicilina, Suprax del grupo de cefalosporinas se usa para tratar infecciones causadas por la bacteria estreptococo viridans.Las cápsulas contienen el principio activo cefixima. La herramienta tiene las siguientes características:
- indicaciones de uso: infecciones del tracto urinario, nasofaringe;
- dosis: hasta 400 mg una vez al día, el curso del tratamiento se establece individualmente;
- contraindicaciones: hipersensibilidad a las penicilinas, cefalosporinas;
- efectos secundarios: diarrea, náuseas, mareos.
El antibiótico tópico Bioparox se prescribe para tratar la infección cuando los viridans afectan la garganta. El medicamento está disponible en forma de aerosol y contiene el principio activo fusafungina. El medicamento tiene las características:
- indicaciones de uso: enfermedades del tracto respiratorio superior causadas por bacterias grampositivas y gramnegativas, incluidos estreptococos;
- dosis: 4 veces al día, una inyección;
- efectos secundarios: lagrimeo, ardor, tos;
- contraindicaciones: intolerancia a los componentes, niños menores de tres años, asma bronquial.
Métodos populares
La infección estreptocócica causada por el agente causante de los viridanos, difiere rápidamente, requiere el uso obligatorio de medicamentos antibacterianos. El tratamiento de enfermedades con la ayuda de la medicina tradicional puede convertirse en parte del régimen de tratamiento. Streptococcus viridans de la faringe puede eliminarse mediante tratamiento antiséptico de la cavidad oral. Las decoraciones hechas de flores de manzanilla, caléndula, hojas de eucalipto, una cuerda se utilizan para enjuagar, ayudan a:
- destruir el patógeno;
- eliminar mecánicamente las bacterias del cuerpo.
Para preparar el caldo, debe verter una cuchara de cualquiera de estas plantas con un vaso de agua hirviendo e insistir durante una hora. Enjuague su boca con una solución tibia varias veces al día. Con daños en los riñones, el sistema urinario, es útil hacer una decocción de bayas, arándanos. La composición tiene un efecto antiséptico, inmunoestimulante, se toma por vía oral en medio vaso, tres veces al día. Por prescripción necesita:
- Vierte 0,5 litros de agua en la sartén.
- Ponga una cucharada de bayas y hojas secas de arándanos.
- Poner en un baño de agua.
- Párate por 30 minutos.
- Insistir en la hora.
- Colar.
Para aumentar las defensas del cuerpo durante la infección, es útil beber propóleos, disueltos en leche tibia. Un buen efecto es dado por el uso de formulaciones preparadas a partir de plantas inmunoestimulantes. Se deben verter dos cucharadas de materias primas con agua hirviendo (0,5 litros), mantenidas bajo la tapa durante una hora. Tomar 100 ml por la mañana y por la tarde. Para el tratamiento, puede usar tales plantas medicinales:
- Raíces de equinácea
- hojas de eleuterococo;
- bayas de rosa mosqueta.

Complicaciones
La infección por estreptococos en ausencia de tratamiento provoca procesos inflamatorios purulentos. Las bacterias viridas, que se propagan a través del torrente sanguíneo, pueden afectar órganos distantes en una semana. Es posible el desarrollo de tales complicaciones:
- inflamación aguda del oído medio;
- abscesos de órganos internos: hígado, riñones;
- daño al tejido pulmonar con la formación de focos purulentos en ellos;
- procesos inflamatorios en el cerebro.
El estreptococo provoca la rápida propagación de la infección a través del sistema linfático. En un corto período de tiempo, los microorganismos viridanos pueden causar consecuencias tan peligrosas:
- enfermedad cardíaca reumática;
- inflamación aguda de los riñones;
- disfunción del sistema nervioso central;
- la propagación de la inflamación a las articulaciones;
- lesiones purulentas de las amígdalas;
- desarrollo de shock tóxico.
Video
252 Streptococcus en un frotis